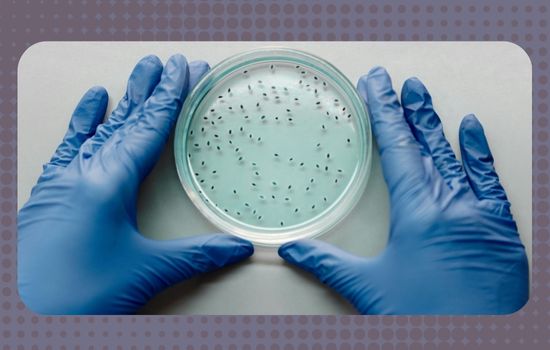

Anúncios
Edición genética CRISPR: cómo funciona es un tema que despierta expectativas reales hoy, no solo fantasías científicas.

En este artículo encontrarás un sumario claro:
Primero, contexto histórico y la base molecular; segundo, mecanismos operativos y variantes; tercero, aplicaciones actuales en salud y agricultura; cuarto, riesgos y debates éticos; y por último, situación en México y proyecciones.
Más que presentar teoría aislada, vas a entender qué ya se hace, qué falta y cómo podría afectar tu vida o tu entorno.
¿Te has preguntado alguna vez cómo unas “tijeras moleculares” pueden cambiar un gen con precisión?
Anúncios
Origen y fundamento molecular
En 2012–2013, los grupos de Jennifer Doudna y Emmanuelle Charpentier describieron cómo el sistema CRISPR-Cas9 podía usarse para editar genomas con precisión, basándose en un mecanismo bacteriano de defensa.
Desde entonces, esa idea evolucionó rápidamente.
El sistema involucra esencialmente dos componentes: una guía de ARN (gRNA) que reconoce la región del ADN a editar, y una proteína Cas (como Cas9) que corta la doble hebra del ADN.
Anúncios
Tras el corte, las células activan sus mecanismos propios de reparación (NHEJ o HDR), que pueden utilizarse para insertar, eliminar o reemplazar secuencias específicas.
Un dato relevante: los costos de edición han bajado dramáticamente, lo que ha ampliado los usos en laboratorios universitarios y empresas emergentes con recursos moderados.
Para visualizarlo mejor, imagina el ADN como una carretera de dos carriles (dos hebras).
El gRNA señala un punto específico, la proteína Cas actúa como remoción selectiva en esa sección, y luego los obreros de reparación interna reconstruyen el asfalto, a veces con variaciones planeadas.
¿Cómo funciona la edición genética CRISPR?
Aquí radica el núcleo de Edición genética CRISPR: cómo funciona. El proceso puede dividirse en varias etapas:
Diseño del ARN guía (gRNA)
Se escoge una secuencia específica del genoma de destino (aproximadamente 20 nucleótidos) que precede un sitio PAM (“Protospacer Adjacent Motif”).
Esa secuencia guiará el sistema para que corte exactamente ahí.
Corte del ADN por la proteína Cas
La proteína Cas (por ejemplo, Cas9) une el complejo gRNA y se posiciona en el ADN. Si la coincidencia es buena y se encuentra el PAM adecuado, Cas9 realiza un corte en ambas hebras del ADN.
Reparación del ADN
Aquí entran los mecanismos celulares:
- NHEJ (unión no homogénea de extremos): Une los extremos rotos de manera rápida, pero introduce errores (deleciones/inserciones).
- HDR (recombinación dirigida homóloga): Si se proporciona un molde de ADN, la célula puede usarlo para reparar la región con la modificación deseada.
Variantes mejoradas
Existen versiones más seguras como base editing (cambiar una base sin romper ambas hebras) y prime editing (usar un ARN-molde que dirige insertaciones/deleciones más precisas), con menor riesgo de efectos fuera del blanco.
Aplicaciones actuales: salud, agricultura y biotecnología
Medicina y terapias genéticas
La edición CRISPR ya se prueba en ensayos clínicos para tratar enfermedades de base genética, como ciertos tipos de ceguera hereditaria y trastornos de sangre.
Se buscan maneras de introducir el sistema en células humanas de manera segura (por virus adenoasociados o nanopartículas).
Por ejemplo: un paciente con mutación puntual en una enzima del hígado podría recibir células editadas ex vivo que corregirían ese defecto y luego reintroducirlas.
También se explora su uso en terapias contra el cáncer: editar células del sistema inmune (como linfocitos T) para mejorar su capacidad de reconocer y atacar tumores.
Agricultura y mejoramiento vegetal
Edición genética CRISPR: cómo funciona es esencial para comprender estos avances agrícolas: ya se han editado genes en maíz para tolerancia a sequía, resistencia a plagas o modificación de rendimiento.
En México, el CINVESTAV utiliza CRISPR-Cas para modificar genes como ZmTMS5 con el fin de inducir esterilidad masculina en líneas híbridas de maíz, optimizando producción.
En plantaciones, se puede introducir el sistema mediante Agrobacterium, biolística o protoplastos.
Luego, los investigadores seleccionan plantas que retienen solo la modificación deseada, sin trazas adicionales de la herramienta CRISPR.
Biotecnología industrial
CRISPR permite modificar organismos microbianos (bacterias, levaduras) para producir compuestos farmacéuticos, biocombustibles o biomateriales.
Por ejemplo, ajustar rutas metabólicas para que una levadura produzca más bioplásticos de carbono renovable.
Riesgos, límites y debates éticos
Efectos fuera del objetivo
Aunque las guías de ARN aumentan especificidad, siempre existe riesgo de “cortes fuera del blanco” (off-target). Por eso los sistemas de validación robusta son esenciales en cada proyecto.
Edición germinal vs somática
La edición somática (en tejidos no reproductivos) no transmite cambios a la próxima generación y es más aceptada.
La edición germinal (en gametos u embriones) genera efectos hereditarios y plantea grandes dilemas éticos: ¿quién decide qué rasgo corregir o “mejorar”?
Acceso desigual y discriminación genética
Si solo ciertos grupos pueden acceder a terapias CRISPR, podría acentuarse la desigualdad en salud. También surge el riesgo de discriminación por datos genómicos mal utilizados.
Regulaciones, gobernanza y seguridad
Muchos países carecen de leyes específicas sobre edición genética.
En México, recientemente la UNAM creó una Unidad de Edición Genética y Criopreservación (UEGC) para servir a investigadores, lo que representa un paso hacia regulación institucional más clara.
Asimismo, el vacío legal ralentiza la aplicación agrícola en México; algunos científicos ya llaman la atención sobre esa parálisis legislativa.
Situación en México y perspectivas futuras
Infraestructura científica nacional
La UEGC de la UNAM es pionera en México y Centroamérica para apoyar investigaciones que requieren generar modelos animales editados genéticamente.
En el campo de plantas, aunque hay avances en ensayos de CRISPR con maíz y otros cultivos, las leyes agrícolas limitan la liberación comercial de variedades editadas fuera del laboratorio.
Científicos mexicanos destacados
Investigadores como Gloria Soberón Chávez, experta en genética molecular, aportan credibilidad al ecosistema científico mexicano.
Además, Luis Rafael Herrera Estrella ha sido pionero en la genética vegetal en México, contribuyendo a variedades resistentes en cultivos.
Desafíos y metas a alcanzar
Para que el público confíe en Edición genética CRISPR: cómo funciona, se requiere transparencia, participación ciudadana y marcos regulatorios sólidos.
Se espera que en la próxima década aparezcan terapias aprobadas que utilicen CRISPR para corregir enfermedades monogénicas, así como cultivos editados resistentes al cambio climático.
También es factible que México regule y promueva la innovación interna, colocándose entre los referentes latinoamericanos en biotecnología.
Tabla comparativa de variantes CRISPR y aplicaciones
Variante / aspecto | Característica principal | Aplicaciones destacadas |
---|---|---|
CRISPR-Cas9 tradicional | Corte de doble hebra con gRNA | Ensayos clínicos, edición vegetal básica |
Base editing | Cambio puntual sin romper ambas hebras | Corregir mutaciones de una sola base |
Prime editing | Inserciones/eliminaciones precisas con molde de ARN | Ediciones más controladas y seguras |
Sistema de entrega | Plásmidos virales, nanopartículas | Terapias humanas, cultivo celular |
Validación / control | Secuenciación de alto rendimiento | Minimizar off-targets, monitoreo posuso |
Leer más: Preguntas más frecuentes en entrevistas
Conclusión
Comprender Edición genética CRISPR: cómo funciona no es sacrificio técnico: es empoderamiento ciudadano.
La edición genética ha dejado de ser solo investigación de laboratorio; ya puede moldear salud, alimentación y medicina del futuro.
Pero su promesa depende de normas claras, supervisión ética y acceso equitativo.
El equilibrio entre innovación y prudencia marcará si CRISPR se convierte en instrumento de bienestar o en fuente de controversia.
Tú, como lector informado, juegas un rol clave al exigir transparencia y beneficiarte responsablemente de estos avances increíbles.
Leer más: Avances en biotecnología: lo que promete la genética
Preguntas frecuentes (FAQ)
¿Cuántas células se deben editar para lograr efecto terapéutico?
Depende del tejido: en órganos como el hígado, bastan unas cuantas decenas o cientos de miles, si logras que proliferen eficientemente.
¿Se puede revertir una edición CRISPR equivocada?
En teoría, mediante nuevas ediciones o mecanismos de reparación, pero esa operación añade complejidad y riesgo.
¿Gracias a CRISPR ya hay cultivos genéticamente editados comercializados en México?
Hasta ahora, no en escala comercial: el marco regulatorio no permite liberar sin más cultivos modificados mediante CRISPR fuera del laboratorio.
¿Qué tan grande es el riesgo off-target?
En ensayos controlados, estos riesgos suelen ser bajos (menores del 1 % de cortes extra detectables si el diseño es cuidadoso), pero cada aplicación exige validación.
¿CRISPR puede usarse en humanos adultos con enfermedades adquiridas?
Sí, se exploran terapias ex vivo (editar células fuera del cuerpo y reinyectarlas) para enfermedades sanguíneas, inmunológicas o cáncer.